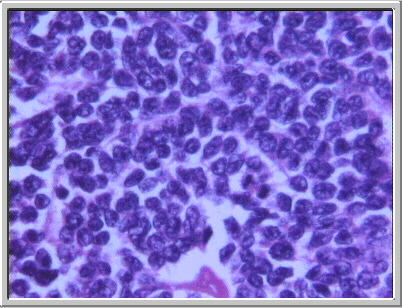
fig. 15

|
 |
|
Fig. 15. Las características citológicas de las células tumorales, entre las que se observa una imagen de mitosis. (HE, X400.) |
Fig. 16. Las células tumorales en las áreas mejor diferenciadas, con algo de citoplasma y núccleo más claro sin nucléolo prominente. (HE, X400.) |
 |
 |
|
Fig. 17. Imagen ultraestructural, muy poco explícita debido a la fijación previa en formol de la muestra procesada, en la que se pueden ver algunas uniones intercelulaares de tipo desmosoma. (X16.500) |
Fig. 18. Imagen de la tinción inmunohistoquímica para demostración de Cam 5.2, con intensa positividad citoplásmica. (IHQ para Cam 5.2, X400.) |
 |
 |
|
Fig. 19. Imagen de la tinción inmunohistoquímica para demostración de cromogranina A, con intensa positividad citoplásmica. (IHQ para cromogranina A, X400.) |
Fig. 20. Histograma de ADN obtenido mediante citometría de flujo en el que se observan las dos poblaciones diploide y aneuploide. |